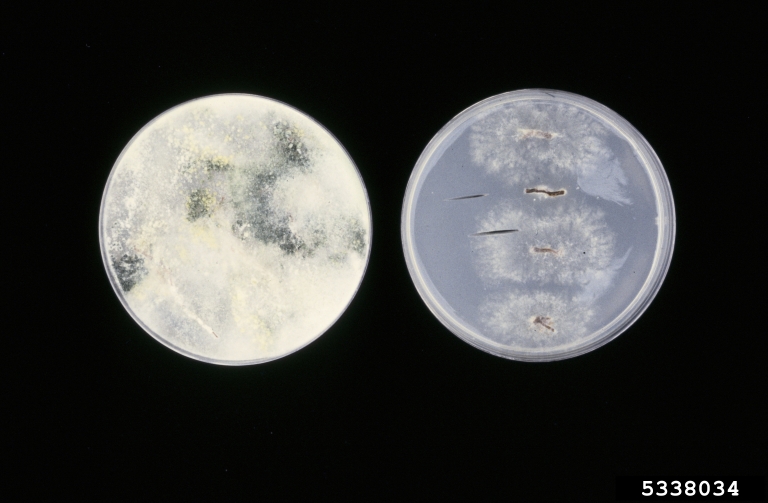

Image Number: 5338034
Photographer:
Organization:
Descriptor:
Culture
Image view:
Close-up
Description:
Nonselective medium vs. selective medium: Trichoderma growing from root pieces on nonselective medium (left) vs. Phytophthora nicotianae growing from root pieces on selective medium containing hymexazole and vancomycin (right)
Image type:
Laboratory
You must attribute the work in the manner specified (but not in any way that suggests endorsement).
Image location:
Node Affiliation:
Image uploaded:
Friday, November 2, 2007
Image last updated:
Monday, December 15, 2008